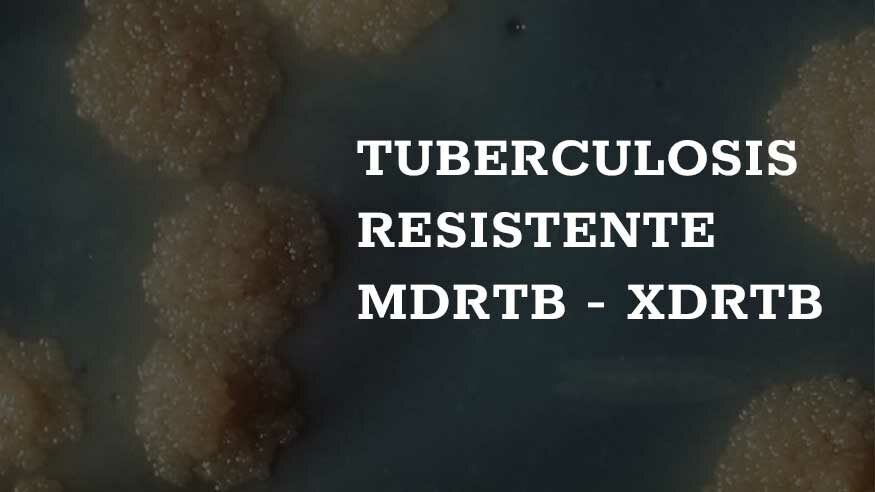

¿Qué es la Tuberculosis Resistente?
En la lucha contra la resistencia a antibióticos necesitamos usar todas las herramientas que tenemos a nuestro alcance, de forma similar a cómo la Reina Roja y Alicia necesitaban correr cuanto daban de sí para quedarse en el mismo sitio.
Nos hemos acostumbrado tanto a los antibióticos que es difícil imaginar una era posterior a los mismos en la que no podamos usarlos. Pero la resistencia a antibióticos es cada vez más habitual entre bacterias patógenas. Además, el desarrollo de otros nuevos se ha ralentizado enormemente.
En este contexto, la pandemia de SARS-CoV-2 nos ha proporcionado una muestra de lo peligroso que es no tener con qué tratar las enfermedades infecciosas. Por eso, la resistencia a los antibióticos se ha convertido en uno de los principales problemas de salud pública actualmente.
Para combatirla, las técnicas de genética funcional (que consisten en determinar la función de los genes) son una de nuestras armas más potentes. Nos permiten entender los mecanismos que causan las resistencias y qué podemos hacer para evitar su aparición. Ahora, con la llegada de las técnicas de secuenciación masiva, podemos usarlas a nivel de todo el genoma.
Se puede producir tuberculosis resistente a los medicamentos cuando los medicamentos que se usan para tratar la tuberculosis se utilizan o se administran de manera incorrecta. Algunos ejemplos de mal uso o administración incorrecta son:
- Cuando las personas no terminan la tanda completa del tratamiento para la tuberculosis.
- Cuando los proveedores de atención médica recetan un tratamiento inadecuado (dosis o tiempo de tratamiento inadecuado).
- Cuando los medicamentos para el tratamiento adecuado no están disponibles.
- Cuando los medicamentos son de mala calidad.
La tuberculosis resistente a los medicamentos es más común en las personas que:
- No toman sus medicamentos para la tuberculosis regularmente.
- No toman todos sus medicamentos para la tuberculosis.
- Vuelven a tener enfermedad de tuberculosis después de haber recibido tratamiento para esa afección en el pasado.
- Provienen de regiones del mundo donde la tuberculosis resistente a los medicamentos es común.
- Han pasado tiempo con alguien que se sabe que tiene enfermedad de tuberculosis resistente a los medicamentos.
Las bacterias plantan cara al tratamiento contra la Tuberculosis
Este es también un problema cada vez más acuciante en la lucha contra la tuberculosis. Cada año se infecta medio millón de personas con tuberculosis multidrogorresistente. Sólo un tercio recibe el tratamiento adecuado y menos del 60 % de los tratados se curan completamente. Esto entorpece la erradicación de la enfermedad, que progresa a un ritmo inferior a lo deseable.
La mayoría de tratamientos antituberculosos que se utilizan hoy en día llevan empleándose desde hace décadas, por lo que ya tenemos cierto conocimiento sobre las bases genéticas de la resistencia para muchos de ellos. Sin embargo, necesitamos más información sobre cómo se adquiere dicha resistencia y si hay formas de volver a sensibilizar las cepas resistentes.
Por otro lado, se están empezando a introducir otros antibióticos de desarrollo más reciente y sabemos muy poco sobre cómo la bacteria adquiere resistencia a los mismos. Por eso, necesitamos también trabajar con ellos para encontrar información sobre la arquitectura genética de la resistencia a estos antibióticos de forma sistemática.
Resistencia a uno de los principales antibióticos: la Isoniazida
En este escenario, en la Unidad de Genómica de la Tuberculosis del Instituto de Biomedicina de Valencia hemos desarrollado una metodología de búsqueda de nuevos genes asociados a la resistencia a uno de los dos antibióticos principales contra la tuberculosis: la Isoniazida.
Además de su importancia clínica, la isoniazida es ideal para este tipo de estudio porque en hasta un 15 % de las bacterias aisladas resistentes la mutación causante no está clara o se desconoce completamente.
Concretamente, en algunos casos no se encuentran mutaciones en ninguno de los genes de resistencia conocidos, por lo que es posible encontrar nuevos candidatos.
Además, al ser un antibiótico tan ampliamente utilizado, existen miles de aislados resistentes de los que conocemos su secuencia genómica completa. Esto es importante porque podremos validar nuestros candidatos mediante datos procedentes de muestras clínicas.
Conocer en profundidad cada gen para poder modificarlos
Para ello, se ha diseñado un estudio pensando en dos objetivos principales: por un lado, ser capaces de encontrar determinantes de resistencia que fueran más allá de los que ya se conocían; por otro, usar el experimento como una prueba de concepto para determinar si se podrían aplicar a nuevos antibióticos. Para llevar a cabo tales estrategias se han combinado dos técnicas: genómica funcional y asociación filogenética.
La genómica funcional, como veíamos al principio, consiste en determinar la función de todos los genes en el genoma. En el caso que nos ocupa, se ha hecho a base insertar un fragmento de ADN en cada gen de forma individualizada, de forma que lo disrumpe e impide que se pueda expresar.
Esta bacteria con el gen inutilizado ha crecido en presencia del antibiótico y ha sido posible ver el efecto. Con este experimento, se ha hallado una lista de genes capaces de modificar la resistencia a isoniazida de la bacteria.
¿Cuáles son los genes responsables de la resistencia?
A continuación, se han comprobado cuáles de estos genes estaban asociados a cambios en resistencia a isoniazida en aislados clínicos. Para ello, se empleó la segunda técnica: asociación filogenética. Esta consiste en reconstruir el árbol evolutivo para una base de datos de miles de aislados y mirar en qué genes de nuestra lista aparecían mutaciones de forma asociada con la aparición de resistencias. Así se extrajo una lista final de genes que estamos muy seguros que están implicados en la resistencia a isoniazida.
Esta es una técnica muy potente porque permite encontrar genes que afectan a la resistencia a un antibiótico aunque no sepamos ni la función del gen ni el mecanismo de acción del antibiótico. Por eso es ideal para estudiar los mecanismos de resistencia a nuevos antibióticos.
Además, es oportuna para comparar entre varios antibióticos y ver posibles patrones de resistencia cruzada, lo cual nos da una información muy valiosa a la hora de diseñar nuevos tratamientos en combinación.
Finalmente, esta técnica se puede usar para buscar nuevas dianas de tratamiento para amplificar la acción del antibiótico y prevenir la aparición de resistencias.
En definitiva, si queremos ganarle la batalla a las bacterias multidrogorresistentes tenemos que aprender a poner en valor este tipo de herramientas, diseccionar los mecanismos de acción y resistencia de los antibióticos y usar esta información para diseñar tratamientos que maximicen el impacto y alarguen la vida útil de los antibióticos. Nos va el futuro en ello.
Fuente del Contenido: theconversation.com









